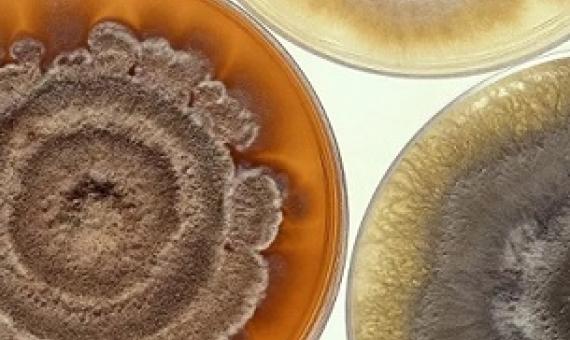
Scientists Find Bacteria so Alien to Human Immune System It Can’t Detect It. Credit - CC0

A new UBC study on the impact of climate change on coral reefs is raising sticky questions about conservation. It found coral in more polluted and high traffic water handled extreme heat events better than a more remote, untouched reef.
Marine scientists aboard Schmidt Ocean Institute's research vessel Falkor have identified likely new marine species and deep sea organisms on nine seamounts that were explored for the first time in the remote Phoenix Islands Archipelago.
The Kiribati island survived droughts due to sacred caves that captured rainfall but rampant phosphate extraction ruined this precious resource...The last decent rain on Banaba was more than a year ago.
A study led by Boston University has discovered deep-sea bacteria so foreign to the human immune system that immune cells do not register it...The researchers harvested the new types of microbial organisms 4,000 meters below the surface in one of the largest and deepest marine protected areas in
Kiribati has had its official warning for failing to effectively tackle illegal, unreported, and unregulated (IUU) fishing rescinded by the European Union following a four-and-a-half-year cooperation between the two parties to help the central Pacific Ocean nation address shortcomings in its fish
Nuclear weapons will soon be illegal.
The idea of moving an entire population en masse is just one of several radical measures under consideration by the island populations most threatened by rising seas. The world’s only atoll nations—in the Pacific, Kiribati, Tuvalu, and the Marshall Islands; in the Indian Ocean, the Maldives—
Kiribati is going under. The tiny nation in the Pacific Ocean is comprised of low-lying islands and atolls — circular land masses with water in the middle — no more than two metres above sea level. It's under threat by rising sea levels caused by climate change.
On 11 December 2018, Kiribati made history by being the first country in the world to have its domestic marine conservation initiative – the Phoenix Islands Protected Area (PIPA) – recognized by the United Nations General Assembly (Resolution A/Res/73/124 titled “Oceans and the Law of the Sea”) a
They contribute only 0.03% of global carbon emissions, but small island developing states, particularly in the Pacific, are at extreme risk to the threats of climate change. Our study, published today in the journal Nature Climate Change, provides the first mega-assessment on